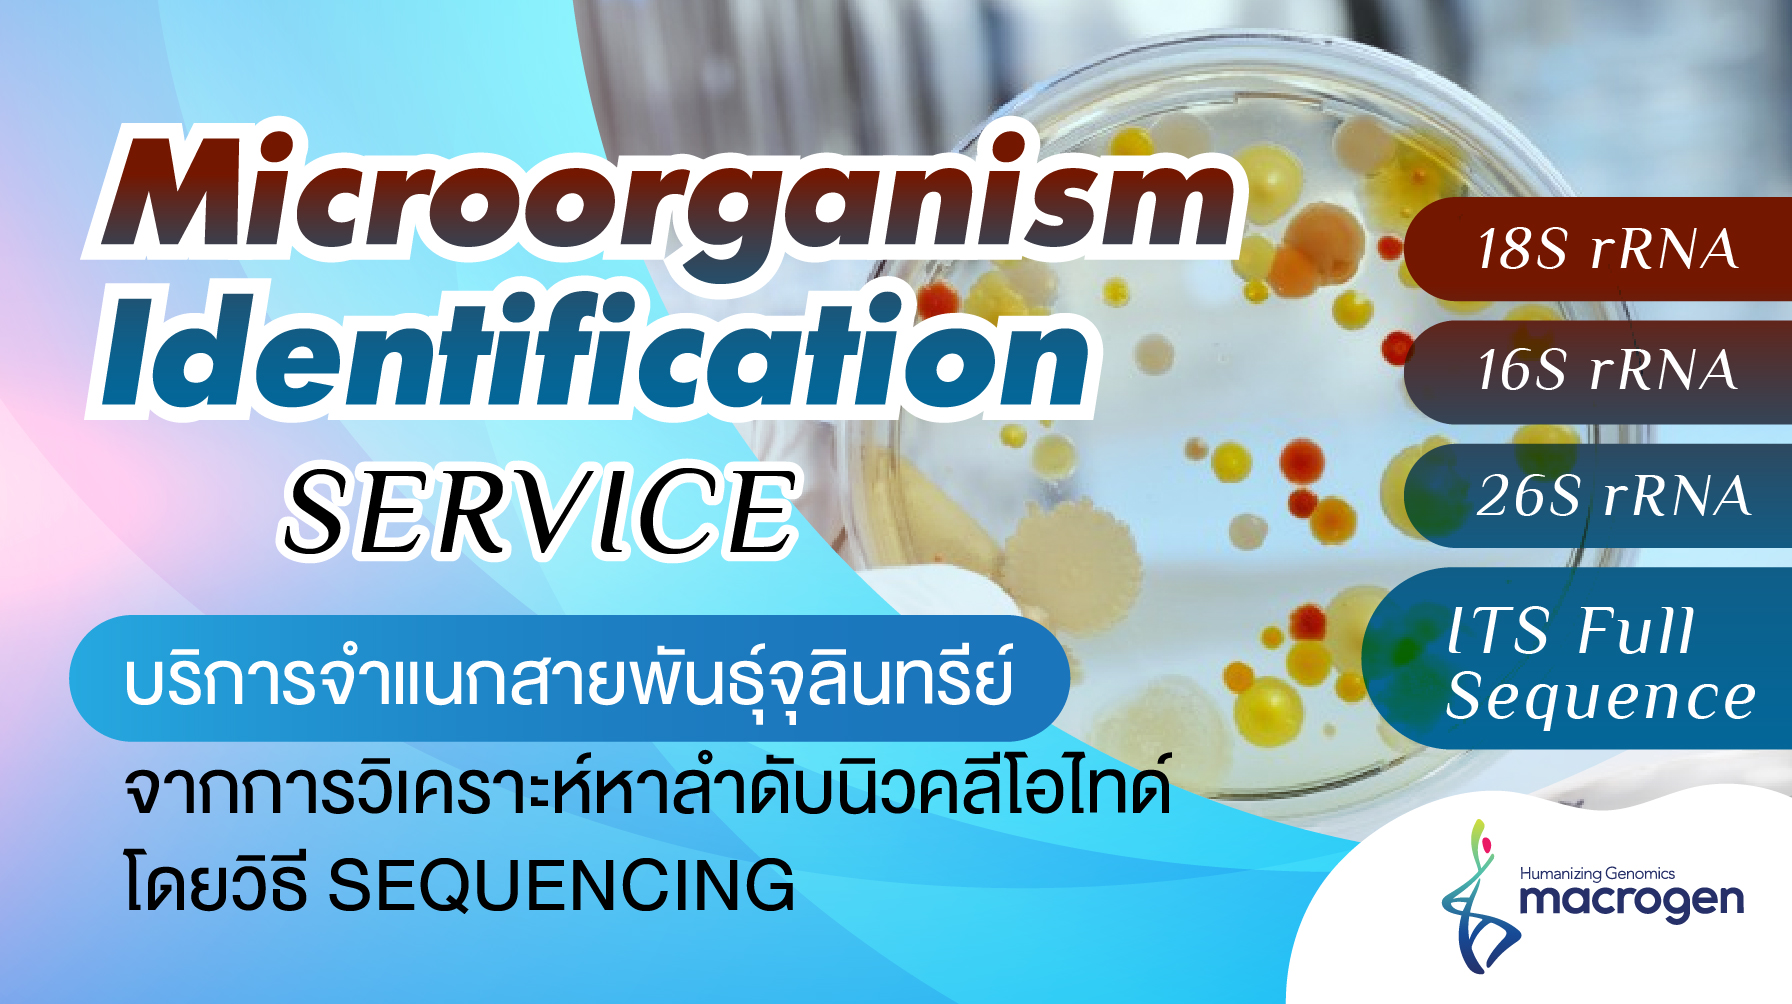

Product Articles
Life Science
Microorganism identification service: 16S/18S/26S rRNA and ITS region
บริการจำแนกสายพันธุ์จุลินทรีย์ จากการวิเคราะห์หาลำดับนิวคลีโอไทด์ (Sequencing) ของบริเวณอนุรักษ์ (Conserve sequence) ซึ่งอยู่บน ribosomal RNA ได้แก่ตำแหน่งของ 16S rRNA, 18S rRNA, 26S rRNA หรือ ITS แบบ full sequence ซึ่งบริการ microorganism identification service สามารถใช้ในการ identify เชื้อได้ทั้ง bacteria และ fungi (filamentous fungus และ yeast) ที่ผ่านการ isolated colony ให้เป็น pure culture หรือเลี้ยงบน selective media เพื่อคัดเลือกกลุ่มเชื้อที่ต้องการ เช่น
การตรวจสอบการปนเปื้อนของเชื้อ Salmonella ในอาหาร จะมีวิธีในการ isolate เชื้อที่ประกอบไปด้วยการเตรียมตัวอย่าง, เพิ่มปริมาณเชื้อ, เจือจาง, culture ใน selective medium และ เลือก pure colony ไปทดสอบต่อไป ซึ่งการทดสอบต่อไปที่จะใช้ในการบ่งชี้สายพันธุ์ของเชื้อแบคทีเรีย อาจทำได้โดยการทดสอบ biochemical test หรือ การ sequencing ดังรูปที่ 1
https://onlinelibrary.wiley.com/doi/epdf/10.1111/1541-4337.12618
.jpg)
รูปที่ 1 การตรวจสอบการปนเปื้อนของเชื้อ Salmonella ในอาหาร
สำหรับ microorganism identification service โดยวิธี sequencing จะให้บริการตั้งแต่ gDNA extraction, PCR amplification, purification, sequencing, และ BI report ด้วยการยืนยันผลผ่านการ Blast หา homology target ของ microorganisms ด้วย rRNA database (NCBI)
1. Prokaryotic microorganism (แบคทีเรีย)
• Target gene: 16S rRNA
.jpg)
• Size: 1,500 bp
• Free universal primer
2. Eukaryotic microorganism (รา หรือ ยีสต์)
การจำแนกสายพันธุ์รา และยีสต์ โดยทั่วไปจะใช้บริเวณ ITS (internal transcribed spacer) แต่ด้วยความแตกต่างกันของบริเวณ ITS ในสิ่งมีชีวิตแต่ละสปีชีส์ จึงทำให้มีการใช้บริเวณอื่น ๆ เพิ่มเติมเพื่อให้เกิดความจำเพาะมากขึ้น เช่น บริเวณของยีน 18S rRNA หรือ บริเวณของยีน 26S rRNA (D1/D2/D3 region)
2.1 จำแนก eukaryotic microorganism ด้วย 18S rRNA region
.jpg)
• Target gene: 18S rRNA
• Size: ~ 1,600 bp
• Free universal primer
2.2 จำแนก eukaryotic microorganism ด้วย 26S rRNA region
.jpg)
• Target gene: 26S rRNA (D1/D2/D3 region)
• Size: ~ 1,300 bp
• Free universal primer
2.3 จำแนก eukaryotic microorganism ด้วย ITS region

• Target gene: ITS region
• Size: ~ 500 bp
• Free universal primer
Workflow of the sequencing process
.jpg)
Additional application of sanger sequencing
• Sequencing of variable regions
• To validate results from next-generation sequencing (NGS) studies
• To verify insertion/deletion, mutations, plasmid sequences
• To study genotyping of microsatellite markers
• To identify variants causing genetic disease
ตัวอย่าง Report → /userfiles/files/Standard_ID_Report-1page.pdf
สำหรับข้อมูลของการให้บริการสามารถติดต่อขอข้อมูลได้ที่อีเมล์ macrogenpm@gibthai.com
บทความโดย: กัลยารัตน์ แก้วนิรัตน์
ตำแหน่ง:Technical Application Specialist for NGS and GeneArt Products









